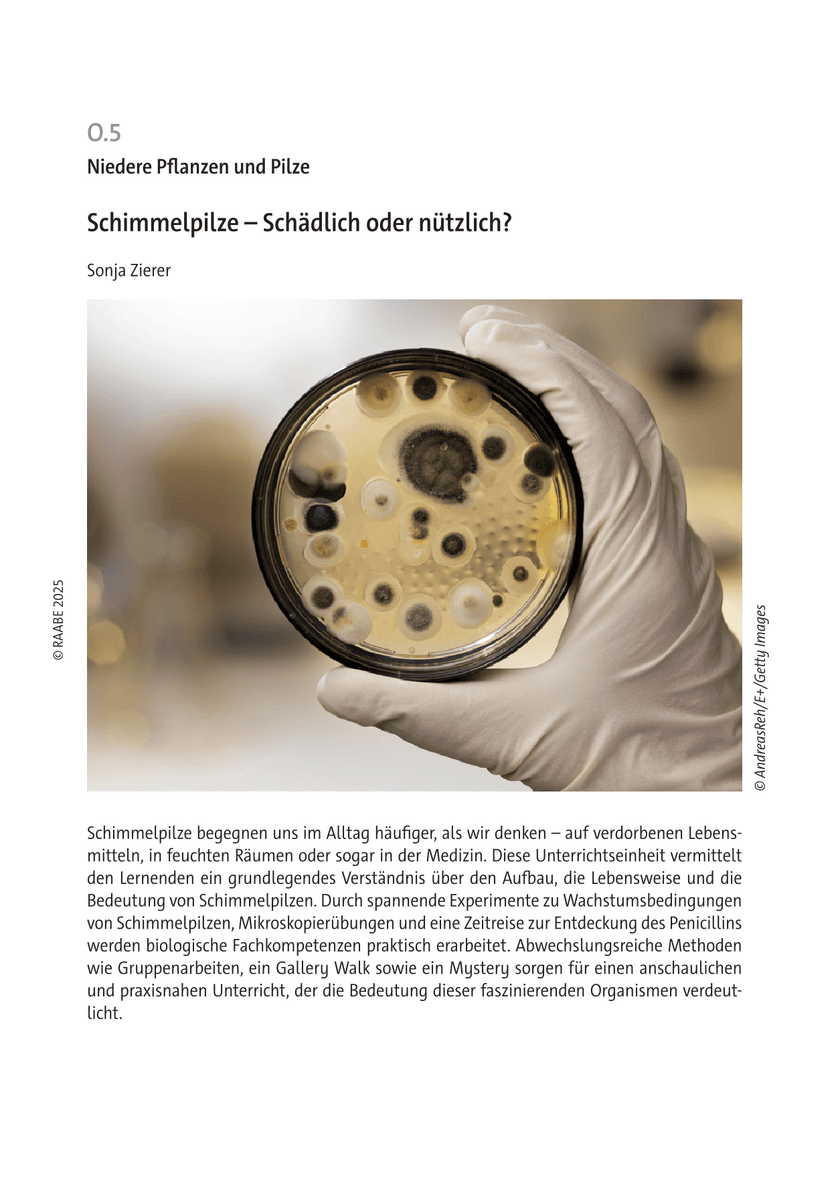

Berufliche Schulen | Gymnasium | Mittlere Schulformen
Biologie
8. | 9. | 10. Klasse
4 - 6 Unterrichtsstunden
Beschreibung
Schimmelpilze begegnen uns im Alltag häufiger, als wir denken – auf verdorbenen Lebensmitteln, in feuchten Räumen oder sogar in der Medizin. Diese Unterrichtseinheit vermittelt den Lernenden ein grundlegendes Verständnis über den Aufbau, die Lebensweise und die Bedeutung von Schimmelpilzen. Durch spannende Experimente zu Wachstumsbedingungen
von Schimmelpilzen, Mikroskopierübungen und eine Zeitreise zur Entdeckung des Penicillins werden biologische Fachkompetenzen praktisch erarbeitet. Abwechslungsreiche Methoden wie Gruppenarbeiten, ein Gallery Walk sowie ein Mystery sorgen für einen anschaulichen und praxisnahen Unterricht, der die Bedeutung dieser faszinierenden Organismen verdeutlicht.
# Mikrobiologie
# Pilze
# Schimmelpilze
# Wachstumsbedingungen
# Penicillin
# Immunbiologie